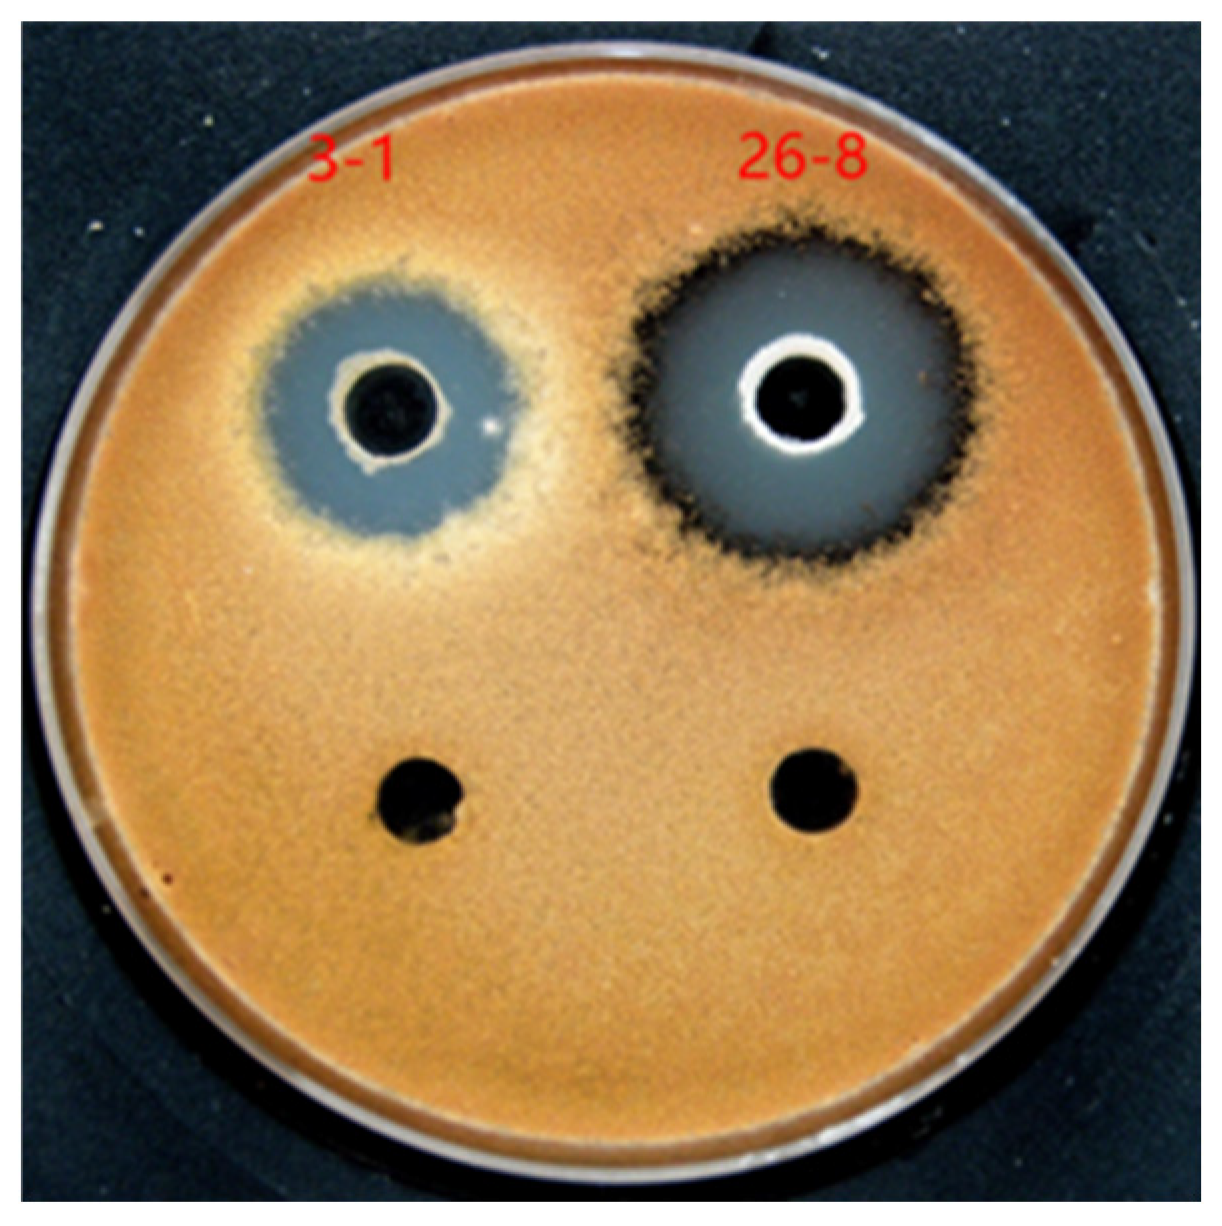
Preprints 120979 g001

Submitted:
11 October 2024
Posted:
12 October 2024
You are already at the latest version
Abstract
Keywords:
1. Introduction
2. Materials and Methods
2.1. Isolation of Soil Microorganisms
2.2. Antimicrobial Screening
2.3. Strain Identification
2.4. Determination of Antagonistic Bacterial Strain Growth Characteristics
2.5. Evaluation of Strain Biocontrol Ability
2.6. Statistical Analysis
3. Results
3.1. Isolation and Screening of Strains
3.2. Identification of Antagonistic Strains
3.3. Determination of Strain Growth Characteristics
3.4. Effects of Strains on Spore Germination and Mycelial Growth of Alternaria Alternata
3.5. Evaluation Results of STRAIN Biocontrol Ability
4. Discussion
5. Conclusions
Author Contributions
Funding
Data Availability Statement
Acknowledgments
Conflicts of Interest
References
- Wojdyło, A.; Carbonell-Barrachina, A.A.; Legua, P.; Hernandez, F. Phenolic composition, ascorbic acid content, and antioxidant capacity of Spanish jujube (Ziziphus jujube Mill. ) fruits. Food chemistry 2016, 201, 307–314. [Google Scholar] [CrossRef] [PubMed]
- Gao, Q.H.; Wu, C.S.; Wang, M. The jujube (Ziziphus jujuba Mill.) fruit: a review of current knowledge of fruit composition and health benefits. Journal of agricultural and food chemistry 2013, 61, 3351–3363. [Google Scholar] [CrossRef] [PubMed]
- Li, M.; Yu, M.L.; Zhang, Z.Q.; Liu, Z.G.; Pan, Y. Control of black spot disease caused by Alternaria alternata on jujube (Ziziphus jujuba Mill. cv. Dongzao) using HarpinXoo protein. The Journal of Horticultural Science and Biotechnology 2012, 87, 250–254. [Google Scholar] [CrossRef]
- Deng, Q.; Lei, X.; Zhang, H.; Deng, L.; Yi, L.; Zeng, K. Phenylalanine promotes biofilm formation of Meyerozyma caribbica to improve biocontrol efficacy against jujube black spot rot. Journal of Fungi 2022, 8(12), 1313. [Google Scholar] [CrossRef]
- Hong, L.; Yang, L.F.; Yang, J.; Guo, J.W.; Cheng, J.S. Screening and optimizing fermentation conditions of Actinomycetes spp. antagonistic to Alternaria sp. causing black spot of jujube. Southwest China Journal of Agricultural Sciences 2018, 31, 1634–1637. [Google Scholar]
- Chen, Q.; Qiu, Y.; Yuan, Y.; Wang, K.; Wang, H. Biocontrol activity and action mechanism of Bacillus velezensis strain SDTB038 against Fusarium crown and root rot of tomato. Frontiers in Microbiology 2022, 13, 994716. [Google Scholar] [CrossRef]
- Zhu, L.H.; Li, X.H.; Shi, Y.F. Identification of Bacillus subtilis SM905 and its inhibitory effect on the conidia of Colletotrichum sp. in Dendrobium officinale. Chinese Journal of Biological Control 2022, 38(2), 469–475. [Google Scholar]
- Zhang, N.N.; Xie, Y.B.; Li, Bin.; Zhang, Z.J.; Yang, Z.M.; Yan, F.F.; Yang, P.; Chen, S.M.; An, D.R. Screening, identification, and fermentation condition optimization of tobacco potato Y virus resistant bacterium ZF-10. Tobacco Science 2023, 1–19.
- Li, X.J.; Yao, C.X.; Qiu, R.; Bai, J.K.; Liu, C.; Chen, Y.G.; Li, S.J. Isolation, identification, and evaluation of the biocontrol potential of a Bacillus velezensis strain against tobacco root rot caused by Fusarium oxysporum. Journal of Applied Microbiology 2023, 134, lxac049. [Google Scholar] [CrossRef]
- Meng, Q.; Hao, J.J. Optimizing the application of Bacillus velezensis BAC03 in controlling the disease caused by Streptomyces scabies. BioContro 2017, 62, 535–544. [Google Scholar] [CrossRef]
- Wang, J.; Zhang, W.; Fan, L.; Xie, A.W.; Yang, H.J.; Wei, S.; Zhai, H.Z.; Hu, Y.S.; Lv, Y.Y. Study on the mechanism of Bacillus subtilis from soil inhibiting the growth of Aspergillus flavus. Journal of Henan University of Technology 2023, 44, 68–74. [Google Scholar]
- Toral, L.; Rodriguez, M.; Bejar, V.; Sampedro, I. Crop protection against Botrytis cinerea by rhizhosphere biological control agent Bacillus velezensis XT1. Microorganisms 2020, 8, 992. [Google Scholar] [CrossRef] [PubMed]
- Chen, Q.; Wang, H. Biocontrol activity and action mechanism of Bacillus velezensis strain SDTB038 against Fusarium crown and root rot of tomato. Frontiers in Microbiology 2022, 13, 994716. [Google Scholar] [CrossRef] [PubMed]
- Zhang, W.W.; Wang, Y.L.; Bi, Y.; Yun, J.M. Screening, identification and biocontrol efficacy of an antagonistic bacterium against potato dry rot. Microbiology China 2018, 45, 1726–1736. [Google Scholar]
- Yang, D.; Du, C.J.; Zhang, J.; Pan, L.F.; Ye, Y.F.; Huang, S.L.; Fu, G. Screening and identification of Bacillus subtilis against banana wilt and its biological characteristics. Chinese Journal of Biological Control 2021, 37(1), 165–171. [Google Scholar]
- Dong, X.Z.; Cai, M.Y. Manual of Common Bacterial System Identification. Beijing: Science Press, 2001.
- Sidorova, T.M.; Asaturova, A.M.; Homyak, A.I. Biologically active metabolites of Bacillus subtilis and their role in the control of phytopathogenic microorganisms. Agric Biol 2018, 53, 29–37. [Google Scholar] [CrossRef]
- Fira, D.; Dimkic, I.; Beric, T.; Lozo, J.; Stankovic, S. Biological control of plant pathogens by Bacillus species. Journal of biotechnology 2018, 285, 44–55. [Google Scholar] [CrossRef]
- Perez-Garcia, A.; Romero, D.; De Vicente, A. Plant protection and growth stimulation by microorganisms: biotechnological applications of Bacilli in agriculture. Current opinion in biotechnology 2011, 22, 187–193. [Google Scholar] [CrossRef]
- Kupfer, M.; Kuhnert, P.; Korczak, B.M.; Peduzzi, R.; Demarta, A. Genetic relationships of Aeromonas strains inferred from 16S rRNA, gyrB and rpoB gene sequences. International Journal of Systematic and Evolutionary Microbiology 2006, 56, 2743–2751. [Google Scholar] [CrossRef]
- De Clerck, E.; Vanhoutte, T.; Hebb, T.; Geerinck, J.; Devos, J.; De Vos, P. Isolation, characterization, and identification of bacterial contaminants in semifinal gelatin extracts. Applied and Environmental Microbiology 2004, 70(6), 3664–3672. [Google Scholar] [CrossRef]
- Dong, N. Symptoms, pathogen analysis, and indoor fungicide screening of jujube black spot disease. Xinjiang: Tarim University, 2015.
- Kuebutornye, F.K.; Abarike, E.D.; Lu, Y. A review on the application of Bacillus as probiotics in aquaculture. Fish & shellfish immunology, 2019, 87, 820–828. [Google Scholar]
- Ye, M.; Tang, X.; Yang, R.; Zhang, H.; Li, F.; Tao, F.; Li, F.; Wang, Z. Characteristics and application of a novel species of Bacillus: Bacillus velezensis. ACS chemical biology 2018, 13, 500–505. [Google Scholar] [CrossRef] [PubMed]
- Khan, A.R.; Mustafa, A.; Hyder, S.; Valipour, M.; Rizvi, Z.F.; Gondal, A.S.; Yousuf, Z.; Iqbal, R.; Daraz, U. Bacillus spp. as bioagents: uses and application for sustainable agriculture. Biology 2022, 11, 1763. [Google Scholar] [CrossRef] [PubMed]
- Abriouel, H.; Franz, C.M.; Omar, N.B.; Galvez, A. Diversity and applications of Bacillus bacteriocins. FEMS microbiology reviews 2011, 35, 201–232. [Google Scholar] [CrossRef]
- Wang, G.F.; Meng, J.F.; Tian, T.; Xiao, X.Q.; Zhang, B.; Xiao, Y.N. Endophytic Bacillus velezensis strain B-36 is a potential biocontrol agent against lotus rot caused by Fusarium oxysporum. Journal of applied microbiology 2020, 128, 1153–1162. [Google Scholar] [CrossRef]
- Chen, L.; Heng, J.; Qin, S.; Bian, K. A comprehensive understanding of the biocontrol potential of Bacillus velezensis LM2303 against Fusarium head blight. PLoS One 2018, 3, e0198560. [Google Scholar] [CrossRef]
- Sun, L.; Wang, W.; Zhang, X.; Gao, Z.; Cai, S.; Wang, S.; Li, Y. Bacillus velezensis BVE7 as a promising agent for biocontrol of soybean root rot caused by Fusarium oxysporum. Frontiers in Microbiology 2023, 14, 1275986. [Google Scholar] [CrossRef]
- Wei, J.; Zhao, J.; Suo, M.; Wu, H.; Zhao, M.; Yang, H. Biocontrol mechanisms of Bacillus velezensis against Fusarium oxysporum from Panax ginseng. Biological Control 2023, 182, 105222. [Google Scholar] [CrossRef]
- Jiang, C.H.; Liao, M.J.; Wang, H.K.; Zheng, M.Z.; Xu, J.J.; Guo, J.H. Bacillus velezensis, a potential and efficient biocontrol agent in control of pepper gray mold caused by Botrytis cinerea. Biological Control 2018, 126, 147–157. [Google Scholar] [CrossRef]
- Li, S.; Xiao, Q.; Yang, H.; Huang, J.; Li, Y. Characterization of a new Bacillus velezensis as a powerful biocontrol agent against tomato gray mold. Pesticide Biochemistry and Physiology 2022, 187, 105199. [Google Scholar] [CrossRef]
- Xue, Y.; Zhang, Y.; Huang, K.; Wang, X.; Xing, M.; Xu, Q.; Guo, Y. A novel biocontrol agent Bacillus velezensis K01 for management of gray mold caused by Botrytis cinerea. Amb Express 2023, 13, 91. [Google Scholar] [CrossRef] [PubMed]
- Li, L.; Wang, R.; Liang, X.; Gai, Y.; Jiao, C.; Wang, M. Characterization of a Bacillus velezensis with antibacterial activity and its inhibitory effect on gray mold germ. Agronomy 2023, 13, 1553. [Google Scholar] [CrossRef]
- Liu, H.; Zeng, Q.; Yalimaimaiti, N.; Wang, W.; Zhang, R.; Yao, J. Comprehensive genomic analysis of Bacillus velezensis AL7 reveals its biocontrol potential against Verticillium wilt of cotton. Molecular Genetics and Genomics, 2021, 296, 1287–1298. [Google Scholar] [CrossRef] [PubMed]
- Sun, Y.; Yang, N.; Li, S.; Chen, F.; Xie, Y.; Tang, C. Mechanism of oxalate decarboxylase Oxd_S12 from Bacillus velezensis BvZ45-1 in defence against cotton verticillium wilt. Journal of Experimental Botany 2024, 75, 3500–3520. [Google Scholar] [CrossRef] [PubMed]
- Cui, L.; Yang, C.; Wei, L.; Li, T.; Chen, X. Isolation and identification of an endophytic bacteria Bacillus velezensis 8-4 exhibiting biocontrol activity against potato scab. Biological Control 2020, 141, 104156. [Google Scholar] [CrossRef]
- Christensen, H.; Olsen, J.E. Phylogenetic relationships of Salmonella based on DNA sequence comparison of atpD encoding the β subunit of ATP synthase. FEMS microbiology letters 1998, 161(1), 89–96. [Google Scholar] [CrossRef]
- Ki, J.S.; Zhang, W.; Qian, P.Y. Discovery of marine Bacillus species by 16S rRNA and rpoB comparisons and their usefulness for species identification. Journal of microbiological methods 2009, 77(1), 48–57. [Google Scholar] [CrossRef]
- Jia, S.; Song, C.; Dong, H.; Yang, X.; Li, X.; Ji, M.; Chu, J. Evaluation of efficacy and mechanism of Bacillus velezensis CB13 for controlling peanut stem rot caused by Sclerotium rolfsii. Frontiers in Microbiology 2023, 14, 1111965. [Google Scholar] [CrossRef]
- Feng, Y.Y.; Li, B.; Yang, Y.; He, J.X.; An, H.; Yan, F.F.; An, D.R. Screening, identification, and antibacterial mechanism research of antagonistic bacteria against tobacco bacterial wilt pathogen. Chinese Journal of Biological Control 2021, 37, 331–339. [Google Scholar]
- Fazle Rabbee, M.; Baek, K.H. Antimicrobial activities of lipopeptides and polyketides of Bacillus velezensis for agricultural applications. Molecules 2020, 25, 4973. [Google Scholar] [CrossRef]
- Vahidinasab, M.; Adiek, I.; Hosseini, B.; Akintayo, S.O.; Abrishamchi, B.; Pfannstiel, J.; Henkel, M.; Lilge, L.; Voegele, R.T.; Hausmann, R. Characterization of Bacillus velezensis UTB96, demonstrating improved lipopeptide production compared to the strain B. velezensis FZB42. Microorganisms 2022, 10, 2225. [Google Scholar] [CrossRef] [PubMed]
- Dong, W.; Long, T.; Ma, J.; Wu, N.; Mo, W.; Zhou, Z.; Jin, J.; Zhou, H.; Ding, H. Effects of Bacillus velezensis GUAL210 control on edible rose black spot disease and soil fungal community structure. Frontiers in Microbiology 2023, 14, 1199024. [Google Scholar] [CrossRef] [PubMed]
- Wang, D.; Gao, Y.; Wu, X.; Zhang, W.; Shu, J.; Zhang, Y.; Zhai, F. Identification of two strains of Bacillus velezensis isolated from Carya illinoensis leaf and their antagonistic effects on pecan black spot pathogen. Chinese Journal of Biological Control 2022, 38, 1572. [Google Scholar]
- Song, C.; Huang, Y.L.; Xie, C.X.; Xv, W. Screening and control effect determination of antagonistic bacteria against black spot disease of jujube fruit[J]. Journal of Henan Agricultural Sciences 2016, 45, 71–75. [Google Scholar]

| Gene segment | Primer | Reaction system | Reaction conditions |
|---|---|---|---|
| 16S rDNA | 27F(5’-AGAGTTTGATCCTGGCTCAG-3’) 1492R(5’-GGTTACCTTGTTACGACTT-3’) |
Mix 12.5 μL primer 0.5 μL template 1.0 μL ddH2O 11.0 μL |
95℃ pre-denaturation 5min. 95℃ degeneration 30s, 58℃ annealing 15s, 72℃ elongation 2min, 20cycles. 72℃ elongation 10min. |
| gyrB | UP-1(5’-GAAGTCATCATGACCGTTCTGCAYGCNGGNGGNAARTTYGA-3’) UP-2r(5’-AGCAGGGTACGGATGTGCGAGCCRTCNACRTCNGCRTCNGTCAT-3’) |
95℃ pre-denaturation 5min. 94℃ degeneration 1min, 54℃ annealing 1min, 72℃ elongation 2min, 25cycles. 72℃ elongation 10min. | |
| rpoB | f(5’-AGGTCAACTAGTTCAGTATGGAC-3’) r(5’-AAGAACCGTAACCGGCAACTT-3’) |
94℃ pre-denaturation 4min. 94℃ degeneration 1min, 51℃ annealing 1min, 72℃ elongation 1min, 25cycles. 72℃ elongation 10min. |
| Antifungal activity | Inhibition diameter (mm) | Number of strains |
|---|---|---|
| - | 0-5 | 14 |
| + | 5-10 | 10 |
| ++ | 10-15 | 14 |
| +++ | 15-20 | 28 |
| ++++ | 20-30 | 44 |
| Items | 26-8 |
|---|---|
| Methyl red test | + |
| V-P text | + |
| Catalase test | + |
| Oxidse test | + |
| Amylolysis | + |
| Nitrate reduction | + |
| H2S production | + |
| Citrate solution test | + |
| Gelatin liquefaction | + |
| D-mannose | + |
| D-mannitol | + |
| D-xylose | + |
| D-arabinose | - |
| Oxidative fermentation of glucose | fermentation |
| Treatment | Germination rate (%) | Inhibition rate (%) |
|---|---|---|
| CK | 88.46±2.05a | - |
| 26-8 | 29.82±0.85b | 66.29 |
| Treatment | Colony diameter (mm± SE) a | Inhibition rate (%) |
|---|---|---|
| CK | 79.04±0.62a | - |
| 26-8 | 39.71±0.31b | 49.76 |
| Time (d) | Spot diameter (% ± SE)a | Inhibition rates (%) | |
| Treatment group | Control group | ||
| 3 | 5.47±0.33a | 10.95±0.77a | 50.01 |
| 6 | 8.39±0.54a | 17.07±1.55b | 50.88 |
| 9 | 10.46±1.04a | 21.33±0.61b | 50.95 |
| 12 | 14.28 ±1.69a | 31.00 ±2.61b | 53.95 |
| 15 | 16.60 ±2.56a | 31.70 ±0.86b | 46.57 |
Disclaimer/Publisher’s Note: The statements, opinions and data contained in all publications are solely those of the individual author(s) and contributor(s) and not of MDPI and/or the editor(s). MDPI and/or the editor(s) disclaim responsibility for any injury to people or property resulting from any ideas, methods, instructions or products referred to in the content. |
© 2024 by the authors. Licensee MDPI, Basel, Switzerland. This article is an open access article distributed under the terms and conditions of the Creative Commons Attribution (CC BY) license (https://creativecommons.org/licenses/by/4.0/).
